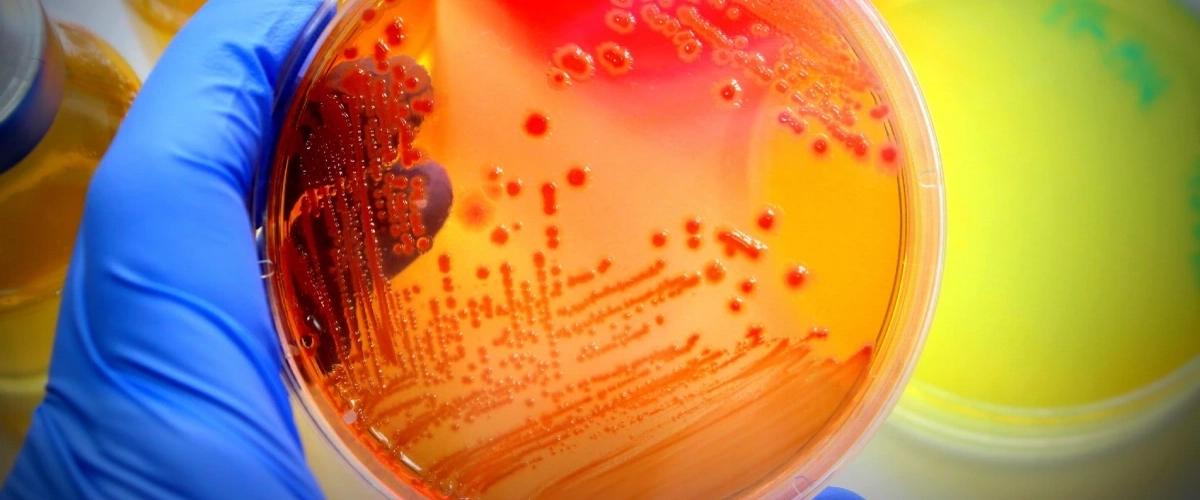
TODO:

Некоторые бактерии развивают устойчивость к антибиотикам через мутации в ДНК. Другие умеют выводить препараты из клеток, чтобы сохранить свое превосходство. Теперь ученые обнаружили, что существует еще один путь — модификация рибосом при воздействии широко используемых антибиотиков, сообщается на сайте Исследовательского центра геномных исследований в Барселоне.
Чтобы прийти к этому выводу ученые протестировали антибиотики стрептомицин и касугамицин, которые спефицифески действуют на рибосомы — органеллы клеток, играющие ключевую роль в синтезе белков. Известно, что рибосомальная РНК часто модифицируется химическими метками, которые могут изменять форму и функцию рибосомы. Клетки используют эти метки для тонкой настройки синтеза белка.
Теперь установлено, что в ответ на антибиотики бактерии изменяют те химические метки, которые особенно важны для связывания с антибиотиком.
По словам автора работы Анны Дельгадо Техедор, бактерии меняют свою структуру ровно настолько, насколько это необходимо для помехи действию препарата. «Это удивительная точность работы, которая выполняется в реальном времени», — подчеркнула она.
В настоящее время ученые продолжают исследовать этот механизм и работают над созданием нового класса антибактериальных препаратов.
Ранее в другой работе ученые нашли механизм защиты метициллин-резистентного стафилококка от антибиотиков. Эта супербактерия несет больший риск для здоровья, однако теперь ученые знают ее слабое место.